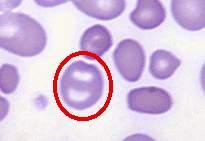

双淡染区红细胞
北京张博士医考临床医师考试辅导—双淡染区红细胞(常见血液学)
北京张博士医考张银合博士携全体优秀老师助大家考试顺利通过!
「张博士医考www.guojiayikao.com整理,如有转载,请注明出处」
上一篇:链杆菌(常见血液学)
下一篇:口腔麻疹粘膜斑(疾病图谱)
- 免费试听
- 网络课
- 直播课
配套图书
红宝书/张博士医考红宝书系列2023新版

学习中心
手机学习





